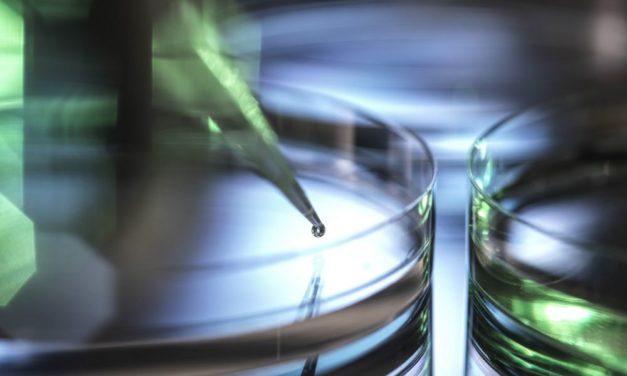
Anträge beim Forschungsfonds FWF steigen stärker als das Budget

Anträge beim Forschungsfonds FWF steigen stärker als das Budget
Es waren erfreuliche, aber auch nicht ganz so erfreuliche Nachrichten, die FWF-Präsident Christof Gattringer am Donnerstag im Haus des Meeres mit Blick über Wien verkündete. Einerseits verzeichnete Österreichs wichtigster Förderer von Grundlagenforschung Rekorde bei der Zahl der geförderten Projekte und den dafür bewilligten Mitteln. Andererseits steigen die Umfänge der beantragten Fördermittel deutlich stärker als das…
Weiterlesen